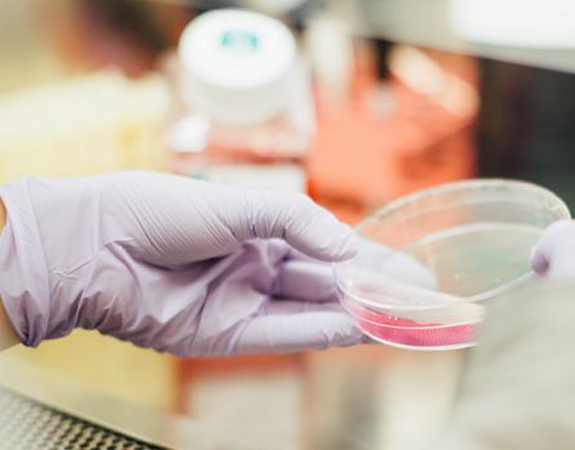

What is Victorious?

Victorious is a research project carried on by the Department of Medical Sciences and Public Health, University of Cagliari, Italy. In the recent years, our research was focused on the cancer biochemistry and pharmacological interferers of the leading tumoral pathways.
One day, our studies gave unexpected results.
More in depth studies let us find a new molecule, which selectively inhibits mitosis in colorectal cancer cells.
In this project we explore in vitro activity of the new molecule on real human samples with cancer developed in colorectal tissues. We believe that the new molecule could be in the future a valid alternative to the currently used chemioteutics, which at the moment lacks cancer selectivity.

What is Valma-Co?

VALMA-CO is the acronym of the project behind Victorious, currently funded by the University of Cagliari (PoC 2022), which allows us to carry out phase 2 of the research on molecule L1 (VALMA-CO – Valorizzazione del brevetto del derivato dell’acido cogico come inibitore selettivo della mitosi nelle cellule tumorali del colon-retto).
L1 is a new molecule, which selectively inhibits mitosis (cell replication process) only in colorectal cancer cells.
Our invention’s Intellectual Property is patented with n. WO202258970_A1 entitled:
Kojic acid derivative as selective inhibitor of mitosis in colorectal and glioblastoma cancer cells.
Over the last 20 years, research has made enormous progress in the treatment of colorectal cancers. The therapies currently available, generally chemotherapy and radiotherapy (combined with a surgical approach in presence of stage I-III tumors), represent a valid treatment, save many lives, and allow numerous patients to continue their daily activities.
However, these therapies have limitations.
In particular, chemotherapy (treatment adopted in the presence of stage IV tumors) is not always selective, requires hospitalization, can have neurotoxic side effects, has a high cost, a high but improvable percentage of effectiveness, a high level of risk for the environment and healthcare workers. Furthermore, new therapeutic approaches, which resort to the use of monoclonal antibodies, also require the exploitation of animals.
Victorious AIMS to overcome these limitations.
The project proposes a new, more selective, green approach that avoids hospitalization, bringing benefits to the patient, the environment, research, and consequently to the entire social system.
Why Victorious?


High selectivity
toward tumor cells

Green Chemistry
reduction of toxicity and side effects

Oral therapy
without hospitalization

Cost savings
and time savings for healthcare
Research approach
The important thing is not to stop questioning.
Curiosity has its own reason for existence.
Albert Einstein
The kojic acid derivative (L1) obtained in our laboratory is a low-cost molecule, produced respecting green chemistry practices (the substrates for the synthesis have low toxicity). The L1 molecule shows the same cytotoxicity as the chemotherapeutics currently in use, but at the same time, even without resorting to the use of monoclonal antibodies, it stands out for its high selectivity towards tumor cells.
The main objective of this project is to show the effectiveness of the L1 molecule in the pharmacotherapy of colorectal cancer, using primary cell lines (tumor and non-tumor) obtained from biopsies of patients affected by colon cancer.
This study therefore aims to understand, through in vitro experiments, whether the L1 molecule could become a valid alternative to the chemotherapy currently in use.
The results obtained must then be confirmed by an appropriate clinical trial. In this way, at a low cost, it will be possible to obtain a new valid, effective and selective drug.
Want to be involved in Victorious research studies?
Why is it important to help research?
Research thrives on support, sharing and reciprocity. Those who have helped research in the past have guaranteed the improvement of current therapies for you, who in turn can help improve therapies for future patients.
What can you do to help our team?
![]() |
Support research by donating a part of your biopsy sample |
![]() |
Sign the consent that will allow us to study the biopsy sample |
![]() |
Try to help those who will be able to benefit from cutting-edge therapies in the future |
What can we do to help you?
|
|
Ensure full transparency and privacy on your data during and after the study |
|
|
Keep your always updated on the status of the research and new potential threapies |
|
|
Try to improve, with your help, available therapies and patients quality of life |
Are you a patient of the Policlinico Universitario AOU Cagliari?
Project: VALMA-CO – Valorizzazione del brevetto del derivato dell’acido cogico come inibitore selettivo della mitosi nelle cellule tumorali del colon-retto
Funded by: University of Cagliari – Università degli studi di Cagliari (call PoC UNICA 2022)
Budget: 80000 €
Duration: December 2023 – December 2024
Scientific coordinator: prof. Terenzio Corongiu


